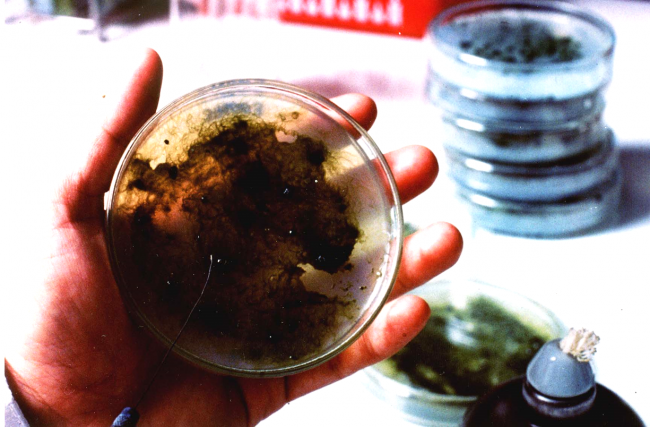

วว. แนะเทคโนโลยีการฟื้นฟูดินหลังน้ำท่วม ช่วยลดการใช้สารเคมี เพิ่มความอุดมสมบูรณ์ให้ดิน

จากสถานการณ์น้ำท่วมครั้งใหญ่ในพื้นที่ภาคเหนือและภาคตะวันออกเฉียงเหนือตอนบนในปี 2567 นี้ ได้สร้างความเสียหายต่อที่อยู่อาศัย ที่ทำกิน ภาคการเกษตร การพาณิชย์ ธุรกิจการค้า รวมถึงนิคมอุตสาหกรรมหลายแห่ง คิดเป็นมูลค่าความเสียหายหลายแสนล้านบาท โดยเฉพาะในพื้นที่ทำการเกษตร นาข้าว พืชไร่ พืชสวน และปศุสัตว์ นับหลายล้านไร่นั้น ในบางพื้นที่ยังมีน้ำท่วมขังนานนับเดือน จนเกิดสภาพน้ำเน่าเสียและดินเป็นกรด บางส่วนถูกกระแสน้ำชะล้างหน้าดินออกไป ทำให้ดินขาดความอุดมสมบูรณ์ โดยการฟื้นฟูสภาพดินที่มีปัญหาเหล่านี้ สามารถทำได้และได้ผลดีโดยการใช้ปุ๋ยชีวภาพ เพื่อให้สภาพธรรมชาติกลับมาดังเดิม
กระทรวงการอุดมศึกษา วิทยาศาสตร์ วิจัยและนวัตกรรม (อว.) โดย สถาบันวิจัยวิทยาศาสตร์และเทคโนโลยีแห่งประเทศไทย (วว.) มุ่งมั่นนำองค์ความรู้วิทยาศาสตร์ เทคโนโลยีและนวัตกรรม (วทน.) ไปใช้ประโยชน์ในการพัฒนาประเทศในทุกมิติและให้เข้าถึงประชาชนทุกระดับตั้งแต่ภาคครัวเรือน ภาคการเกษตร วิสาหกิจชุมชน ธุรกิจ SME ภาคการศึกษา จนถึงภาคอุตสาหกรรม ให้สมกับคำกล่าวที่ว่า “วิทยาศาสตร์และเทคโนโลยี มีไว้เพื่อประชาชนทุกคน”
จากการดำเนินงานของ วว. โดย ศูนย์ความหลากหลายทางชีวภาพ ได้ประสบผลสำเร็จในการวิจัยและพัฒนา “ปุ๋ยชีวภาพ” ที่ผลิตขึ้นจากจุลินทรีย์ชนิดต่างๆ ที่มีประโยชน์ทางการเกษตร ไม่ว่าจะเป็นเชื้อราที่ย่อยสลายแร่ธาตุในดินให้เป็นอาหารแก่พืช แบคทีเรียที่สามารถสร้างปุ๋ยให้แก่พืชได้ รวมถึงสาหร่ายสีน้ำเงินแกมเขียวที่เปลี่ยนก๊าซไนโตรเจนในอากาศให้กลายเป็นสารประกอบไนโตรเจนที่พืชนำไปใช้ประโยชน์ได้ รวมทั้งยังช่วยทำให้ดินร่วนซุย มีสภาพโครงสร้างที่ดีเหมาะแก่การเจริญเติบโตของพืช

โดยเฉพาะ “ปุ๋ยชีวภาพจากสาหร่ายสีน้ำเงินแกมเขียว” จะนิยมนำไปใช้กับนาข้าว เพื่อทดแทนการใช้ปุ๋ยไนโตรเจน ซึ่งในสภาพพื้นที่ทำการเกษตรที่ถูกน้ำท่วมขัง แล้วระดับน้ำลดลงจนเหลือเพียง 10 – 20 เซนติเมตร จะมีความชุ่มชื้นและมีสารอินทรีย์ต่างๆ อยู่มาก ซึ่งเป็นสภาพที่เหมาะสมอย่างยิ่งต่อการเจริญเติบโตของสาหร่ายสีน้ำเงินแกมเขียว
ทั้งนี้เมื่อหว่านเม็ดปุ๋ยชีวภาพจากสาหร่ายสีน้ำเงินแกมเขียวลงไปในอัตรา 50 กิโลกรัมต่อไร่ และทิ้งไว้ 2 สัปดาห์ สาหร่ายสีน้ำเงินแกมเขียวจะเพิ่มจำนวนมากขึ้น จากการใช้สารอินทรีย์ น้ำและแสงแดด ในการเจริญเติบโต สามารถตรึงก๊าซไนโตรเจนที่มีอยู่ทั่วไปในอากาศให้อยู่ในรูปสารประกอบแอมโมเนียมแล้วปลดปล่อยลงสู่น้ำและดิน รวมถึงช่วยปรับสภาพความเป็นกรด-ด่างของดินและโครงสร้างของดินให้เหมาะสมต่อการเจริญเติบโตของพืช
เมื่อระดับน้ำลดลงจนเกือบแห้งแล้ว เกษตรกรสามารถทำการไถพรวนเตรียมดินเพื่อเพาะปลูกได้ทันที ซึ่งเป็นการช่วยลดค่าใช้จ่ายในการฟื้นฟู ช่วยลดระยะเวลาในการเตรียมดิน อีกทั้งยังช่วยเพิ่มความอุดมสมบูรณ์ให้กับดิน และไม่เป็นอันตรายต่อสิ่งแวดล้อมและเกษตรกรผู้ใช้ จึงเป็นการลงทุนเพียงเล็กน้อย แต่ได้ประโยชน์หลายต่อทั้งในระยะสั้นและระยะยาว

หากเกษตรกรสนใจที่จะนำปุ๋ยชีวภาพจากสาหร่ายสีน้ำเงินแกมเขียวมาใช้ฟื้นฟูดินหลังน้ำท่วม สิ่งที่ต้องพิจารณาเป็นอันดับแรก คือ ข้อมูลบนฉลากกระสอบปุ๋ย โดยต้องมีรายละเอียดครบถ้วนที่ฉลากหรือกระสอบปุ๋ย ทั้งเลขทะเบียนปุ๋ยต้องระบุชนิดและจำนวนของสาหร่ายสีน้ำเงินแกมเขียว อัตราการใช้ ชื่อที่อยู่ของผู้ผลิตและวันที่ผลิต นอกจากนี้หากมีตรารับรองอื่นๆ จากหน่วยงานราชการ สถาบันการศึกษา หรือตรามาตรฐานที่เป็นสากล จะช่วยให้มั่นใจยิ่งขึ้นได้ว่า ปุ๋ยชีวภาพจากสาหร่ายฯ ที่ซื้อมาใช้นั้นมีคุณภาพ และได้ประโยชน์คุ้มค่ากับเงินที่จ่ายไป
สำหรับเกษตรกรที่มีทุนน้อย สามารถใช้วิธีขยายปริมาณปุ๋ยชีวภาพจากสาหร่ายสีน้ำเงินแกมเขียวก่อนที่จะนำไปใช้ได้ โดยผสมปุ๋ยชีวภาพ 1 กิโลกรัม กับปุ๋ยหมัก 50 กิโลกรัม ทั้งนี้หากไม่สามารถหาซื้อปุ๋ยหมักได้ สามารถใช้ดินร่วนที่มีเศษใบไม้ทับถมตามโคนต้นไม้ เช่น ดินใต้ต้นก้ามปู หรือดินรอบๆ กอไผ่ นำมาใช้ทดแทนปุ๋ยหมักได้

Waterbodies pollution by blooming blue-green algae (Cyanobacteria) is world environmental problem. Concept of polluted nature.
โดยเมื่อผสมส่วนผสมทั้งหมดดังกล่าวแล้ว ให้หว่านลงไปในบ่อดินขนาด 4 – 5 ตารางเมตร ลึก 10 เชนติเมตร แล้วเทน้ำลงไปจนเต็มบ่อ ทิ้งไว้ประมาณ 2 สัปดาห์จนน้ำแห้ง สาหร่ายสีน้ำเงินแกมเขียวจะจับตัวกันเป็นแผ่นบางๆ เกษตรกรสามารถนำมาใช้เป็นปุ๋ยชีวภาพในการปรับปรุงฟื้นฟูสภาพดินได้ โดยปุ๋ยชีวภาพจากสีน้ำเงินแกมเขียว1 กระสอบ ขนาด 50 กิโลกรัม สามารถขยายปริมาณได้ถึงประมาณ 200 กิโลกรัม และใช้ได้กับพื้นที่ประมาณ 4 – 5 ไร่ ซึ่งช่วยประหยัดค่าใช้จ่ายลงได้จำนวนมาก แต่ได้ประสิทธิภาพในการฟื้นฟูดินที่ใกล้เคียงกัน แม้จะใช้ระยะเวลามากกว่าเล็กน้อย ทั้งนี้หากเกษตรกรใช้ปุ๋ยชีวภาพติดต่อกันเป็นระยะเวลานาน จะช่วยลดปริมาณการใช้ปุ๋ยเคมีลงได้กว่า 50% โดยที่ดินจะมีความอุดมสมบูรณ์มากขึ้นและได้ปริมาณรวมถึงคุณภาพของผลผลิตทางการเกษตรมากยิ่งขึ้นด้วย
เกษตรกรหรือผู้สนใจ สอบถามข้อมูลรายละเอียดเพิ่มเติมเกี่ยวกับ “ปุ๋ยชีวภาพจากสาหร่ายสีน้ำเงินแกมเขียว” ติดต่อได้ที่ ศูนย์ความหลากหลายทางชีวภาพ วว. โทร. 0 2577 9058 (นายประธาน โพธิสวัสดิ์) อีเมล brc@tistr.or.th เว็ปไซต์ www.tistr.or.th/Bio-Industries/BRC/ หรือที่ “วว. JUMP”








